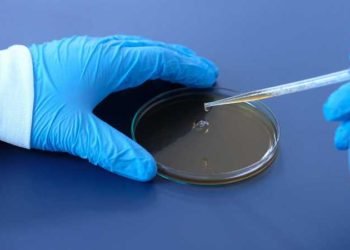
DCGI issues guidelines for manufacturing coronavirus vaccination

Brain aneurysm successfully treated using a contour device
January 25, 2021
Health Talk by Dr. Nutan Ray
September 23, 2020
Free medical camp held in Rohtak to honour legacy of Dr. S.N. Chugh
November 4, 2024
Climate Change: The Hidden Catalyst of Viral Outbreaks
September 25, 2023